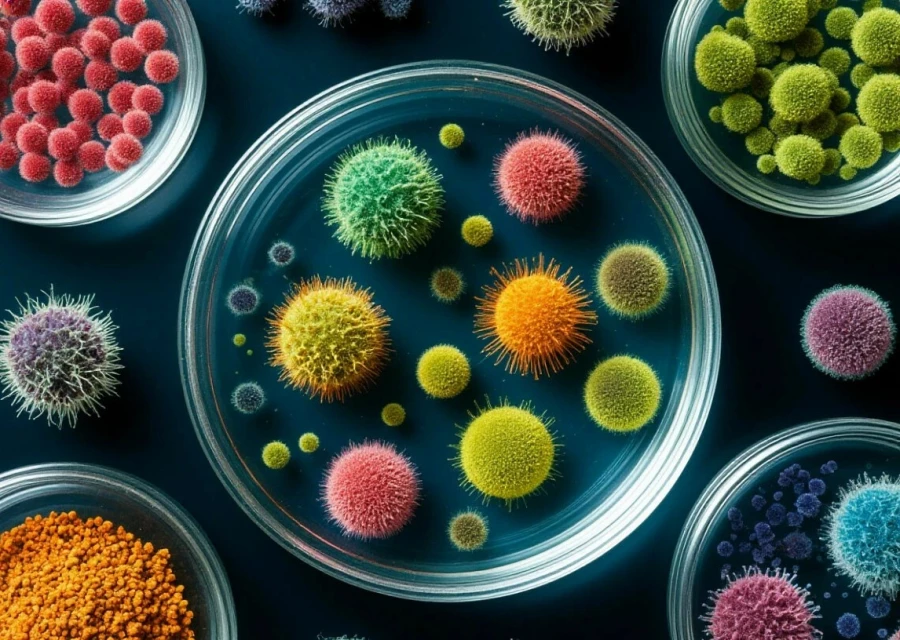
Бактерии. Микробы.

Никаких сомнительных ингредиентов
До 2026 года покупка чак-чака была вопросом везения. Покупатель мог приобрести как эталонный десерт, так и продукт низкого качества, содержащий заменители меда и большое количество консервантов. Также существовал риск, что при приготовлении десерта были нарушены базовые требования гигиены.
Причина в том, что массовое производство чак-чака регулировалось преимущественно техническими условиями отдельных предприятий, что приводило к существенному расхождению в качестве, составе и внешнем виде продукции.
«Учитывая, что речь идет о качестве национального блюда более десятка народностей, проживающих в России, введение единого ГОСТ Р 72229-2025 «Изделия кондитерские. Чак-чак. Технические условия» защитило, можно сказать, государственные интересы», — подчеркивают эксперты Центра.
В разработке первого ГОСТа на чак-чак участвовали крупные производители кондитерских изделий и высококвалифицированные специалисты в области кондитерского производства.
«Стандарт установил четкие измеримые критерии, учитывающие современные требования к качеству и безопасности готового продукта и исключающие введение в заблуждение потребителя, который должен приобрести чак-чак на основе натурального сырья, а не «сомнительных» ингредиентов», – отметила начальник отдела сертификации Ирина Лебедева.

Стандарты качества
Стандарт содержит четкое определение чак-чака как кондитерского изделия и подробно описывает технологические этапы его производства, в том числе содержит требования к упаковке. В документе зафиксированы физико-химические показатели: влажность, кислотность, содержание сахара и другие параметры.
По словам экспертов Центра, главная цель изменений – обеспечить строгое соответствие готовой продукции нормативам по массовой доле влаги, жира и общего сахара, закрепленных стандартом.
Так, ГОСТ на чак-чак допускает использование следующего сырья: мука пшеничная хлебопекарная высшего или первого сорта, яйца куриные пищевые или меланж яичный, мед натуральный; сахар белый, масло растительное для фритюра, ванилин и другие разрешенные ароматизаторы.

Массовая доля жира в готовом изделии должна составлять не менее 30%, а содержание общего сахара (в пересчете на сахарозу) – не более 30%. Эти параметры гарантируют традиционную текстуру и вкус десерта.
Важно отметить, что ГОСТ на чак-чак устанавливает требования к информации для потребителя: на этикетке должны быть указаны состав, пищевая ценность, условия хранения, срок годности и данные производителя. Допускается выпуск как классического варианта, так и глазированного чак-чака (покрытого шоколадом или кондитерской глазурью), а также украшенного орехами, сухофруктами или кондитерскими посыпками – при условии, что эти добавки указаны в маркировке.
«Один из самых важных разделов посвящен показателям безопасности, где документ нормирует микробиологические показатели (плесени, дрожжи, патогенные микроорганизмы), содержание токсичных элементов (свинец, кадмий, мышьяк, ртуть), уровень пестицидов и микотоксинов (включая афлатоксин В1), радионуклиды (цезий-137, стронций-90)», – отметила Ирина Лебедева.
Параллельно с этим производитель должен убедиться, что аккредитованная лаборатория располагает всеми необходимыми методиками, поверенным оборудованием и квалификацией персонала для проведения полного спектра испытаний, предусмотренных новым стандартом – от органолептической оценки до определения содержания токсичных элементов и микотоксинов.
Чак-чак – это настоящий кладезь полезных веществ и низкомолекулярных незаменимых органических соединений, являющихся необходимыми для правильного функционирования и существования человека. Среди них витамины: B4 (8,7 %), B1 (8,5 %), B6 (8,5 %), E (7,9 %), B9 (6,6 %), B5 (6,1 %), B7 (3,8 %), B2 (3,1 %), B12 (1,3 %), которые могут поднять настроение и быстро восполнить калории, особенно после физических нагрузок.
Десерт полезен для иммунитета и стабильного обмена веществ, благодаря натуральному меду в составе.
Средняя калорийность классического чак-чака – около 360 ккал на 100 г десерта. Поэтому есть его нужно порционно и нечасто, поскольку блюдо может способствовать набору веса.

Как выбрать вкусный чак-чак
При выборе продукта обращайте внимание на внешний вид. Форма чак-чака должна быть в виде конуса, пирамиды, полусферы из отдельных обжаренных в масле палочек из теста размером не более 1 см в диаметре, не более 5 см в длину, равномерно залитых медом или медово-сахарным сиропом.
Цвет должен быть равномерным, от светло-желтого, золотистого до светло-коричневого.
Вкус и запах – свойственный для данного вида изделия, с выраженным ароматом и привкусом меда, без постороннего запаха.
Поверхность десерта должна быть неровной и не подгорелой.

Вид в разрезе – мелкопористые палочки, равномерно пропеченные, с отдельными вздутиями и небольшими пустотами внутри отдельных единиц.
Рекомендуемые условия хранения чак-чака: температура – от 13 до 23 градусов, относительная влажность воздуха – не более 75%. Срок годности при соблюдении условий хранения – до 90 суток.







